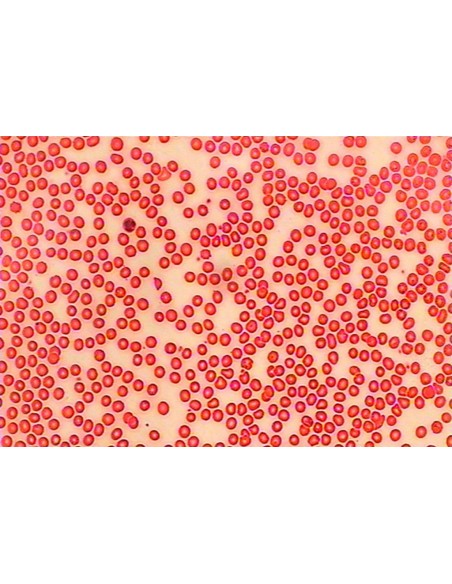

Cosul de cumparaturi
Nu mai exista produse in cosul tau
Iti mai recomandam
Urmatoarele Produse:
- ocular WF10X înclinat la 45°, rotație 360°
- cu cameră CMOS 1/3" și 1.3MP încorporată,
- rezolutie: 1280x1024,conectare USB 2.0
- imaginile foto si video afisate de calculator se pot salva in formatele BMP, JPG.
- obiective DIN, acromatice 4x, 10x, 40x , opțional 100x
- mărire 40x, 100x, 400x opțional 1000x
- platină 115x125mm cu deplasare mecanică în două direcții X-70mm , Y-20mm , cu limitator reglabil
- diafragma iris ϕ2-ϕ30mm și filtru ϕ32mm
- condensator ABBE tip N.A. 1.25 (ϕ2-ϕ30mm)
- iluminare inferioară încorporată, cu bec cu incandescență de 20W
- reglaj focus coaxial macro și micro 14mm/0.1mm
- cerințe de sistem: Hardware: USB2.0, CPU: Intel P4 , 256Mb, HDD:512Mb rezoluție PC:1024X768, Win2000, WinXP
- greutatea netă: cca. 2.6 Kg
No reviews